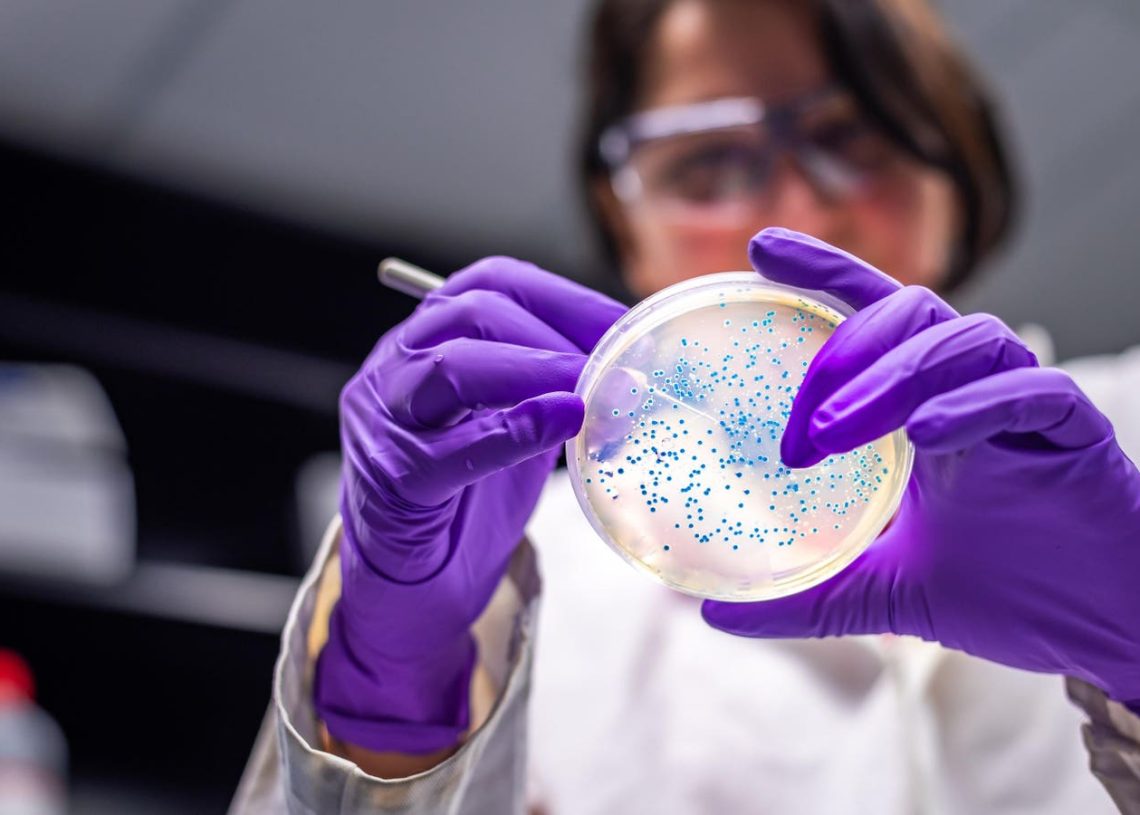
Biotechs Bounce. New Highs For Ideaya, Olema And Vertex.

Biotechs rallied this week, a strong indication that “risk on” is back on after Fed Chair Jerome Powell said interest rates won’t be raised again right now.
This sector is the non-value stock sector — investors going for growth like to place money here when they feel that a bottom may be in place.
I’m not an expert on the reasons that a single biotech may be better than another, but I do follow price trends and that’s what makes the group interesting.
The group’s upward blast on Friday came on increased volume, a sign (not a guarantee) that these stocks are of interest again to those gauging that reward may now be worth the risk.
Biotech Price Charts: An ETF and 3 Stocks:
The SPDR S&P Biotech Exchange Traded Fund consists of 135 stocks, trades with a price-earnings ratio of 19 and at about 3 times book value. Considered a benchmark for the sector, here’s the weekly price chart:
You can see how it peaked at $175 in early 2021 and now goes for $71.46, a drop of 58%. The ETF had a decent rally this week but still trades beneath both its 50-day moving average (the blue line) and its 200-day moving average. Note that, so far, it’s managed to stay above the mid 2022 low.
The daily chart for the SPDR S&P Biotech ETF looks like this:
Buyers stepped it up this week and the biotech benchmark seems to have bottomed — perhaps temporarily, at least — at $64. Note that the ETF continues to trade below its moving averages, even with this significant rally.
Ideaya Biosciences hit a new 52-week high and then backed off. Here’s the daily price chart:
The Nasdaq-traded “clinical stage precision medicine oncology” company has a market capitalization of $1.81 billion. Unlike many other biotechs, the stock has traded upward since late April and remains above up trending 50-day and 200-day moving averages.
Olema Pharmaceuticals is another Nasdaq biotech hitting new highs. The daily price chart is here:
The company, based in San Francisco, California, focuses on cancer treatments for women. Note that the stock could have been purchased at $3 in April and is now priced at $16.59, an extraordinary gain over just 6 months. It’s moves like this that attract the “growth” investor.
Vertex Pharmaceuticals works on treatments for a number of diseases including sickle cell anemia. The Nasdaq traded biotech has a market cap of $97.10 billion. The daily price chart looks like this:
After the stock hit new highs this week, sellers took profits up there at the $380 level. Vertex traded at $286 as recently as March, as you can see. It hasn’t traded below that up trending 200-day moving average since that month.
I am no longer on Twitter — I’ve moved to Threads.net.
Read the full article here